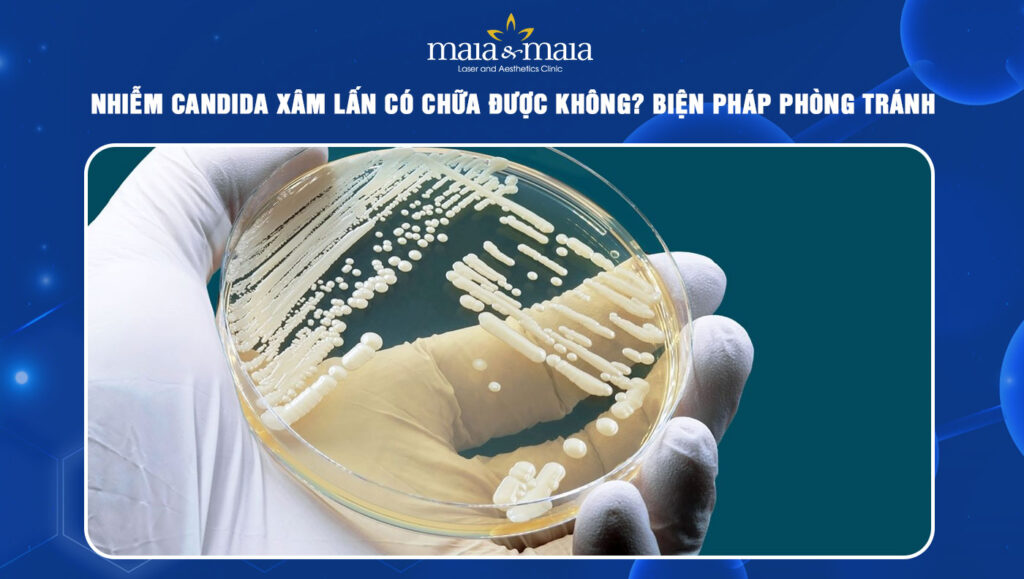
nhiễm nấm candida xấm lấn

Nhiễm Candida xâm lấn là một trong những bệnh lý nguy hiểm có nguy cơ đe dọa tính mạng nếu không được phát hiện và điều trị kịp thời. Vậy dấu hiệu nhận biết là gì, nguy hiểm đến mức nào và điều trị ra sao? Cùng Phòng khám Chuyên khoa Da liễu Maia&Maia tìm hiểu thông tin chi tiết qua bài viết sau.
I. Nhiễm Candida xâm lấn là tình trạng gì?
Đây là tình trạng nhiễm nấm hệ thống nghiêm trọng xảy ra khi nấm Candida vượt qua hàng rào bảo vệ tự nhiên để xâm nhập vào máu và lan tỏa đến các cơ quan nội tạng quan trọng. Khác với nhiễm Candida nông chỉ gây khó chịu tại chỗ, thể xâm lấn có nguy cơ cao gây nhiễm trùng huyết, suy đa cơ quan và đe dọa trực tiếp đến tính mạng người bệnh.
Đặc biệt, diễn tiến của bệnh lý vô cùng nhanh, triệu chứng không đặc hiệu và khó chẩn đoán sớm, nhất là ở những bệnh nhân đang điều trị hồi sức tích cực hoặc suy giảm miễn dịch. Nếu không được can thiệp kịp thời bằng thuốc kháng nấm phù hợp, tỷ lệ biến chứng nặng và tử vong có thể tăng cao.
Tác nhân gây bệnh chủ yếu là các chủng nấm men thuộc chi Candida, điển hình là Candida Albicans, ngoài ra còn gặp Candida Glabrata, Candida Tropicalis, Candida Parapsilosis… Những loại nấm này vốn tồn tại tự nhiên trong cơ thể người nhưng sẽ bùng phát và tấn công khi hàng rào miễn dịch suy yếu hoặc mất cân bằng nội môi.

II. Đối tượng có nguy cơ cao bị nhiễm Candida xâm lấn
Không phải ai nhiễm Candida cũng tiến triển thành thể xâm lấn. Bệnh thường gặp hơn ở những nhóm đối tượng có hệ miễn dịch suy giảm hoặc can thiệp y tế kéo dài, bao gồm:
- Người đang điều trị hồi sức tích cực (ICU)
- Bệnh nhân ung thư đang hóa trị, xạ trị
- Người ghép tạng, ghép tế bào gốc
- Người nhiễm HIV/AIDS giai đoạn tiến triển
- Bệnh nhân dùng kháng sinh phổ rộng kéo dài
- Người đặt Catheter tĩnh mạch trung tâm, ống thở, ống thông tiểu lâu ngày
- Trẻ sinh non, người cao tuổi có bệnh nền mạn tính
III. Triệu chứng nhận biết bệnh nhiễm nấm sâu
Nhiễm nấm Candida xâm lấn thường khó phát hiện sớm do triệu chứng không điển hình và dễ nhầm lẫn với nhiễm khuẩn máu. Các biểu hiện khác nhau tùy cơ quan bị xâm lấn, tuy nhiên mọi người có thể gặp phải những dấu hiệu sau:
- Sốt kéo dài, không đáp ứng với kháng sinh
- Ớn lạnh, mệt mỏi, suy kiệt nhanh
- Hạ huyết áp, rối loạn ý thức trong trường hợp nặng
- Đau tại cơ quan bị xâm lấn như gan, thận, tim, não…
- Rối loạn chức năng đa cơ quan

IV. Chẩn đoán và điều trị nhiễm nấm Candida xâm lấn
Ngay khi nghi ngờ nhiễm nấm xâm lấn, mọi người hãy thăm khám ngay với bác sĩ để được chẩn đoán chính xác và chỉ định biện pháp điều trị kịp thời:
1. Phương pháp chẩn đoán
Quá trình chẩn đoán đòi hỏi sự phối hợp chặt chẽ giữa đánh giá lâm sàng và các xét nghiệm nấm Candida chuyên sâu. Bác sĩ dựa vào tiền sử bệnh, yếu tố nguy cơ kết hợp với các phương pháp cận lâm sàng như cấy máu tìm vi nấm, xét nghiệm dấu ấn sinh học nấm, kỹ thuật sinh học phân tử và chẩn đoán hình ảnh sau siêu âm, CT, MRI hoặc sinh thiết mô để đánh giá tổn thương cơ quan.
2. Phác đồ điều trị
Sau khi được chẩn đoán tổn thương, mọi người cần tuân thủ dùng thuốc trị nấm Candida toàn thân được bác sĩ chỉ định đường tĩnh mạch trong giai đoạn đầu. Các nhóm thuốc phổ biến gồm Echinocandin, Azole hoặc Amphotericin B tùy vào mức độ bệnh, chủng nấm và tình trạng người bệnh.
Việc lựa chọn thuốc, liều lượng và thời gian điều trị cần tuân thủ nghiêm ngặt theo phác đồ y khoa để tránh gây kháng thuốc, tái phát nặng hơn. Do đó, mọi người cần lưu ý các vấn đề quan trọng sau:
- Không tự ý dùng thuốc kháng nấm hoặc ngưng thuốc giữa chừng khi chưa có chỉ định
- Theo dõi sát chức năng gan, thận trong quá trình điều trị
- Loại bỏ hoặc thay thế Catheter, dụng cụ xâm lấn nếu cần
- Điều trị đồng thời các bệnh nền, tăng cường miễn dịch
- Tái khám đúng lịch để đánh giá đáp ứng điều trị

V. Cách phòng ngừa nhiễm nấm xâm lấn cho đối tượng nguy cơ
Đối với các nhóm nguy cơ cao, phòng ngừa nhiễm Candida xâm lấn là yếu tố then chốt giúp giảm tỷ lệ biến chứng và tử vong. Theo đó, các biện pháp dự phòng cần được thực hiện đồng bộ, đặc biệt trong quá trình chăm sóc và điều trị y khoa kéo dài gồm:
- Sử dụng kháng sinh đúng chỉ định, tránh lạm dụng kháng sinh phổ rộng kéo dài
- Tuân thủ nghiêm ngặt nguyên tắc vô khuẩn khi đặt Catheter, ống thở và các dụng cụ xâm lấn
- Theo dõi sát tình trạng nhiễm trùng ở bệnh nhân hồi sức tích cực hoặc suy giảm miễn dịch
- Kiểm soát tốt các bệnh nền như đái tháo đường, suy thận, bệnh gan mạn tính
- Tăng cường dinh dưỡng, nâng cao sức đề kháng và phục hồi thể trạng
- Hạn chế sử dụng thuốc ức chế miễn dịch hoặc Corticoid khi không cần thiết
- Khám và can thiệp sớm khi xuất hiện các dấu hiệu nghi ngờ nhiễm nấm
Bài viết trên đã cung cấp thông tin chi tiết cho mọi người về tình trạng nhiễm Candida xâm lấn. Hy vọng với những thông tin trên, mọi người đã biết cách nhận biết dấu hiệu ban đầu và phòng ngừa nấm đúng cách. Nếu còn bất kỳ thắc mắc nào khác liên quan, mọi người hãy liên hệ ngay với Phòng khám Chuyên khoa Da liễu Maia&Maia qua hotline 032.845.1188 để được hỗ trợ tốt nhất.
TƯ VẤN 24/7 HOTLINE: 032.845.1188
Mọi thông tin của khách hàng đều được bảo mật
Phòng khám chuyên khoa Da liễu Maia&Maia:
- Facebook: Phòng khám Chuyên khoa Da liễu Maia&Maia
- Hotline: 18004888 và 032.845.1188
- Cơ sở 1: Số 11 Hoàng Cầu, Đống Đa, Hà Nội
- Cơ sở 2: Số 197 Lê Thánh Tông, Võ Cường, Bắc Ninh
- Cơ sở 3: Số 24 Nguyễn Khuyến, Hà Đông, Hà Nội